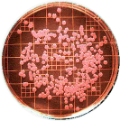

|
Database of Biochemical Tests of Pathogenic Enterobacteriaceae Family A tool to identify microbes using minimal biochemical tests |

|
 |
Database of Biochemical Tests of Pathogenic Enterobacteriaceae Family A tool to identify microbes using minimal biochemical tests |
|